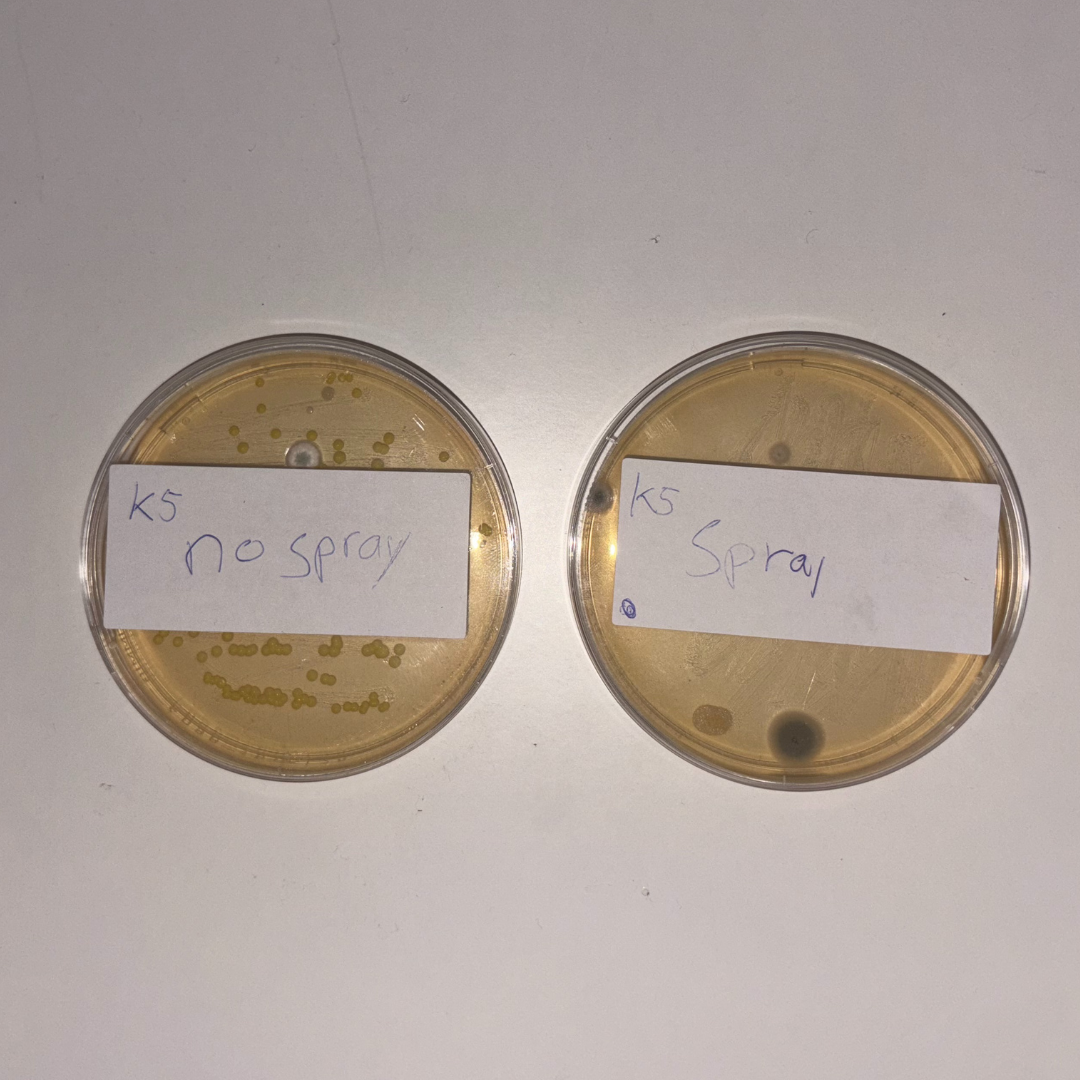
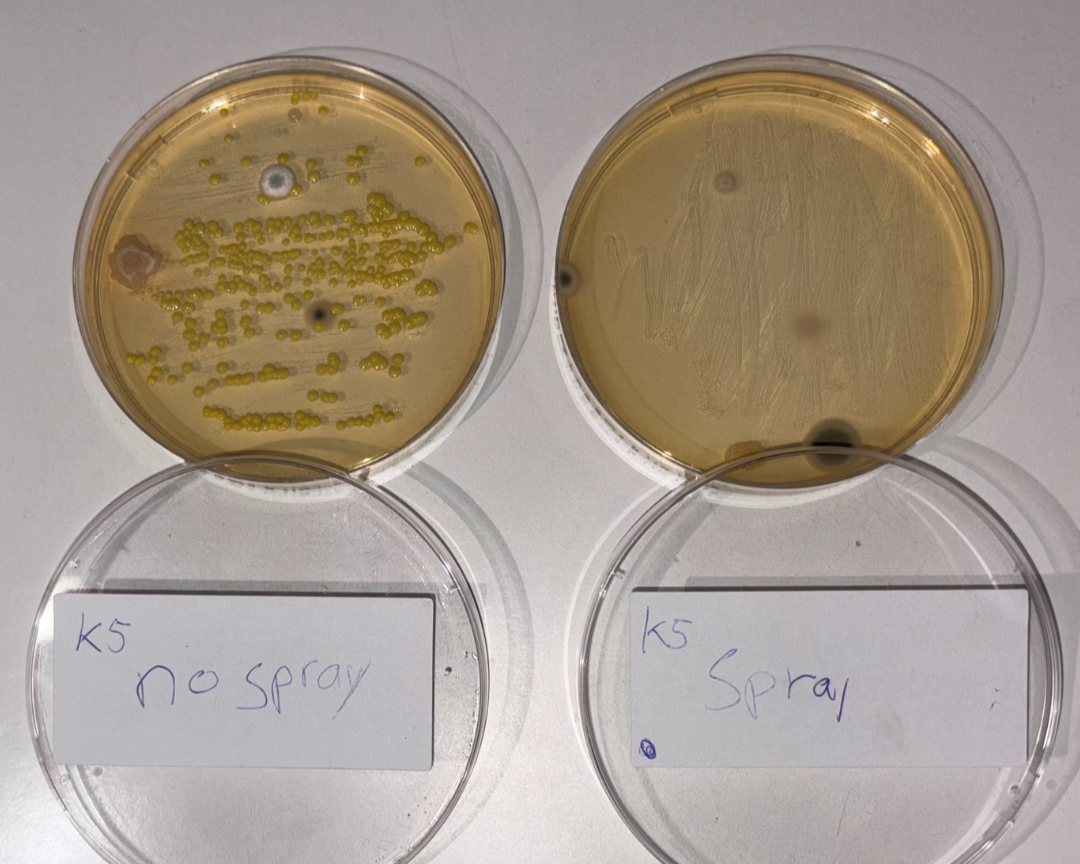

- Page
- Bewijs van werking
Bewijs van werking
De test: "deurklink sample"
Om de werking van ons apparaat te testen, hebben we een sample genomen van een veelgebruikte deurklink met een wattenstaaf. Dit is daarna verdeeld over twee petrischalen:
- No Spray (zonder licht en zonder vloeistof)
- Spray (met blauw licht, zonder vloeistof)
De schalen zijn vervolgens 7 dagen bewaard onder dezelfde omstandigheden.
📸 Resultaten
- In de schaal No Spray zie je duidelijk een grote hoeveelheid bacteriegroei: de kolonies vullen bijna de hele schaal.
- In de schaal Spray (alleen behandeld met blauw licht) zie je nauwelijks groei: slechts een paar kleine plekjes.
Dit verschil laat zien dat ons blauwe licht direct effect heeft op bacteriën, zelfs zonder dat er een vloeistof is gebruikt.
✅ Conclusie
Deze simpele test laat duidelijk zien dat ons apparaat met blauw licht de bacteriegroei aanzienlijk vermindert. Zelfs zonder vloeistof is het resultaat al overtuigend.
Getest voor jou:

Wat is bluelighttechniek?
De bluelighttechniek maakt gebruik van speciaal blauw LED licht om bacteriën, virussen en schimmels op een veilige en natuurlijke manier te doden — volledig zonder chemicaliën of schadelijke stoffen.
Deze methode is contactloos, milieuvriendelijk en voorkomt resistentie, waardoor het ideaal is voor desinfectie, infectiepreventie en een duurzame hygiënische oplossing.


